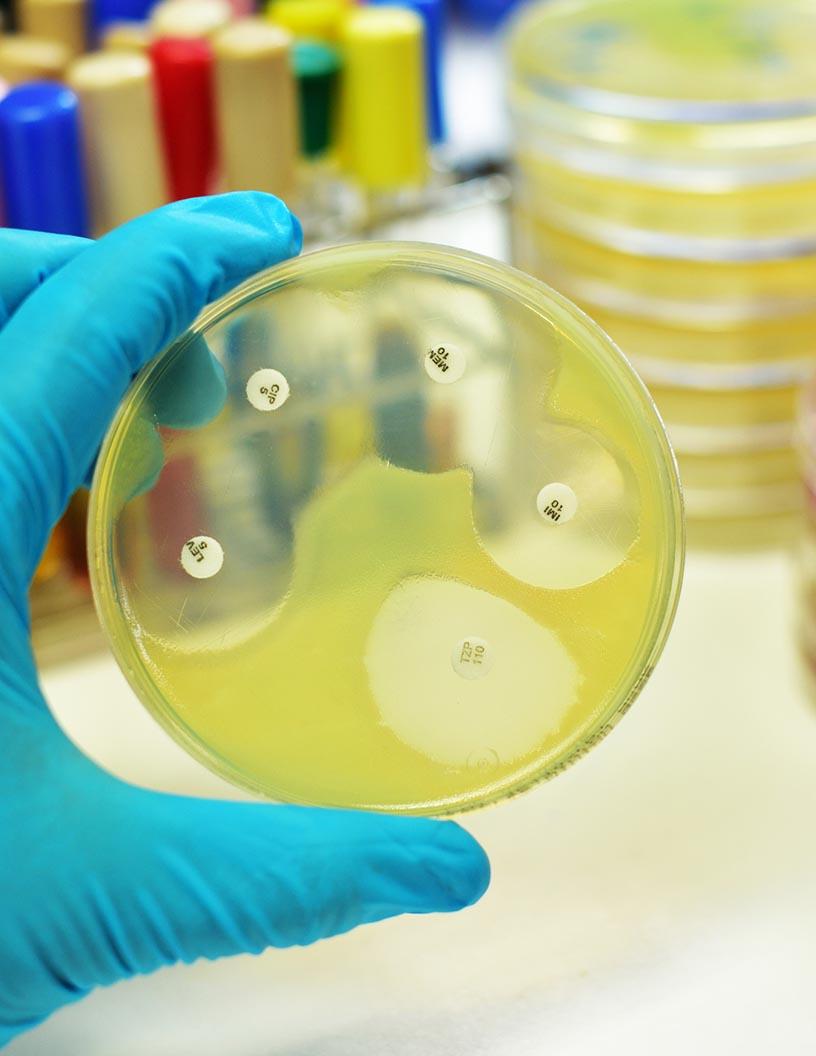
Antimicrobial Susceptibility Testing Market Analysis, Size, and Forecast 2025-2029: North America (US and Canada), Europe (France, Germany, Spain, UK), Middle East and Africa , APAC (China, India, Japan, South Korea), South America , and Rest of World (ROW)

Life Sciences Tools & Services Market Research Reports
{{ totalResults }} reports found
for "{{ selecteCategory }}"
No results found